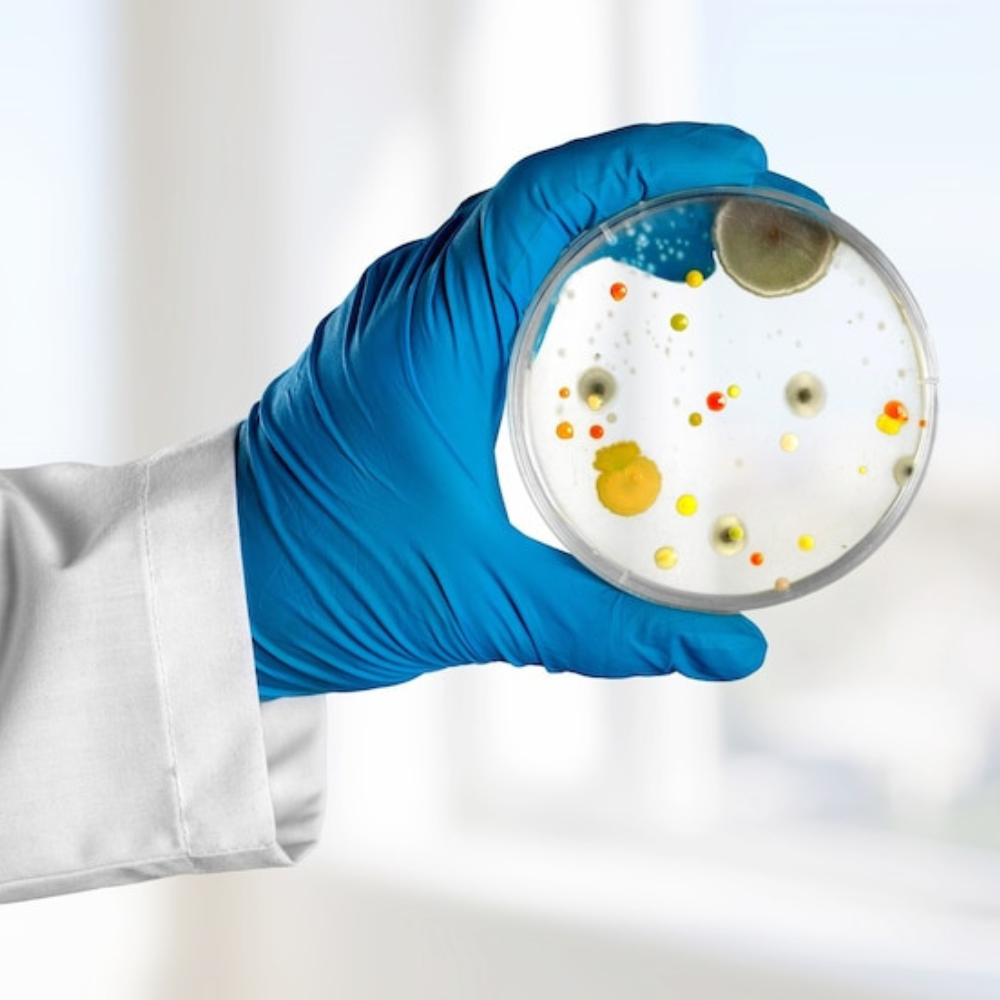
Laboratoire_analyses_services_biochzaw
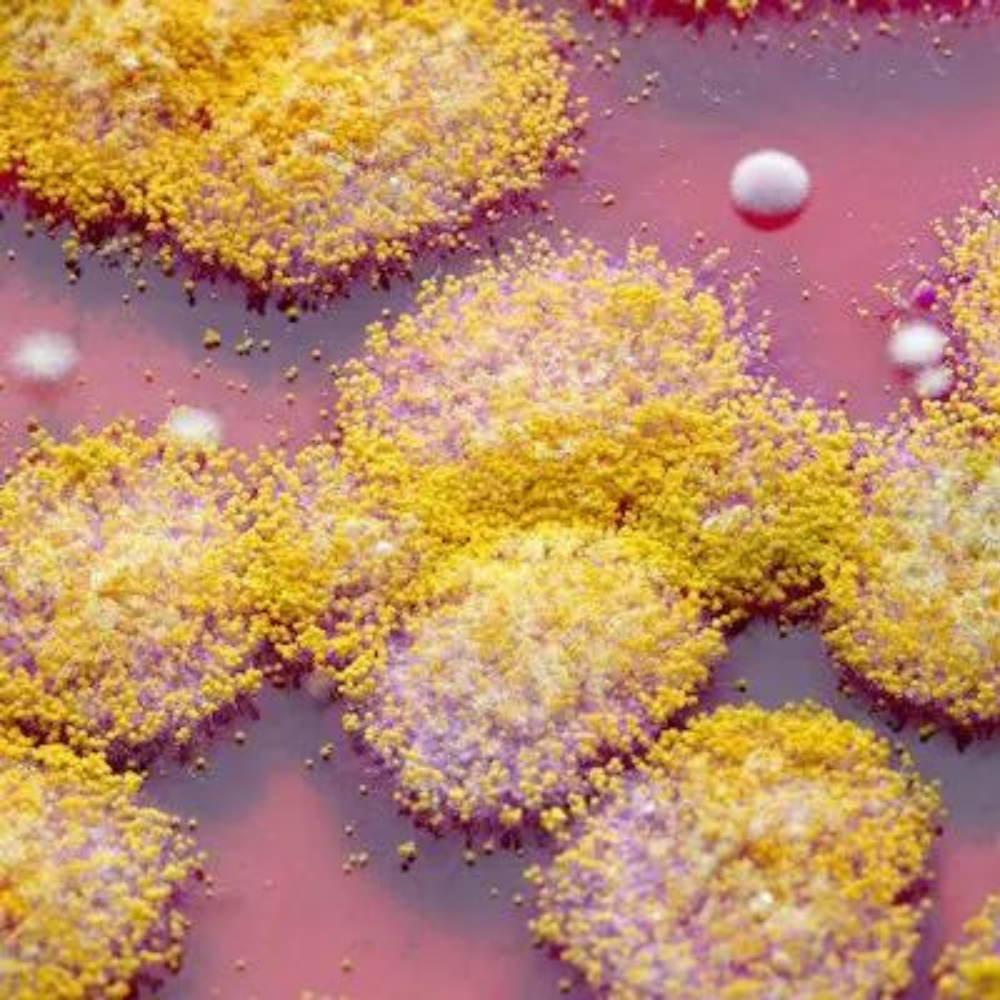
Laboratoire_analyses_services_XX14
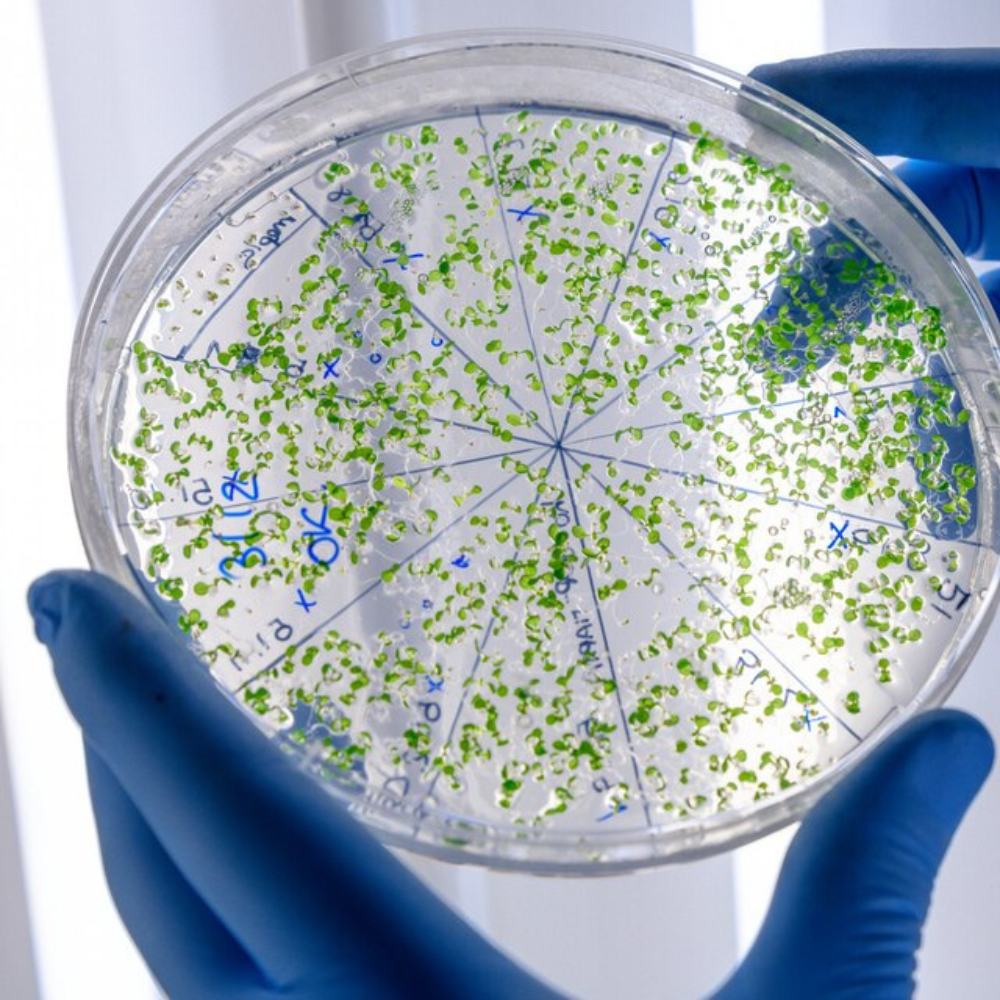
Laboratoire_analyses_services_XX13

Analyses Disponible
Analyses Disponible
Biochimie :
La biochimie est au cœur de notre approche globale de l’évaluation de la santé. Nous offrons des analyses biochimiques approfondies pour évaluer les niveaux de substances chimiques dans le corps, fournissant des informations cruciales pour le diagnostic et le suivi de diverses conditions médicales, y compris les troubles métaboliques.

Hormonologie :
La hormonologie est cruciale pour comprendre et évaluer les déséquilibres hormonaux qui peuvent affecter divers aspects de la santé. Notre labo propose une gamme complète d’analyses hormonales pour aider les cliniciens à diagnostiquer et traiter des conditions telles que les troubles thyroïdiens, les déséquilibres hormonaux sexuels et d’autres affections liées aux hormones.

Immunologie :
Notre service d’immunologie se concentre sur l’étude du système immunitaire. Nous fournissons des analyses spécialisées pour évaluer la réponse immunitaire du corps, diagnostiquer les troubles immunitaires et surveiller l’efficacité des traitements. Ces informations sont essentielles pour comprendre et traiter un large éventail de conditions liées au système immunitaire.

Parasitologie :
Notre service de parasitologie se consacre à l’identification et à l’étude des parasites responsables de diverses maladies. Grâce à des techniques spécialisées, nous fournissons des analyses précises pour diagnostiquer les infections parasitaires, ce qui est essentiel pour une gestion efficace et ciblée des affections parasitaires.
Sérologie :
La sérologie est la branche de notre laboratoire qui se concentre sur l’étude des sécrétions sériques, notamment des anticorps. Nous utilisons des techniques avancées pour détecter la présence d’anticorps spécifiques, aidant ainsi au diagnostic des infections virales, bactériennes, et parasitaires, ainsi que des maladies auto-immunes.

Hémobiologie :
Notre service d’hémobiologie se consacre à l’étude des composants du sang. Nous analysons avec précision les cellules sanguines, les facteurs de coagulation, et les marqueurs spécifiques pour diagnostiquer diverses conditions médicales telles que les troubles hématologiques, les infections et les maladies auto-immunes.

Mycologie :
La mycologie est la branche dédiée à l’étude des champignons. Nous effectuons des analyses spécialisées pour diagnostiquer les infections fongiques, que ce soit au niveau cutané, pulmonaire ou systémique. Notre expertise permet une identification précise des agents pathogènes fongiques et aide à la prescription de traitements adaptés.
Bactériologie :
Notre service de bactériologie se consacre à l’identification et à la caractérisation des bactéries. Nous réalisons des analyses approfondies pour diagnostiquer les infections bactériennes, déterminer leur sensibilité aux antibiotiques, et guider ainsi les médecins dans la prescription de traitements efficaces.
Spermiologie :
Notre service de spermiologie se concentre sur l’analyse approfondie du sperme. Nous fournissons des évaluations détaillées de la qualité du sperme, incluant la concentration, la motilité, la morphologie, et d’autres paramètres essentiels. Ces analyses sont cruciales pour évaluer la fertilité masculine et guider les démarches de procréation médicalement assistée.
